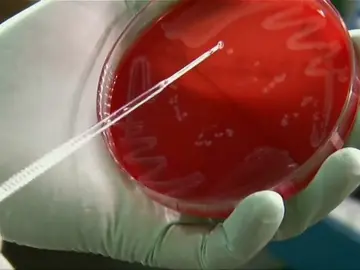
Investigadores españoles diseñan antibióticos que atacan solo las bacterias 'malas' y evitan resistencias Investigadores españoles diseñan antibióticos que atacan solo las bacterias 'malas' y evitan resistencias

Alucinarás con la cantidad de bacterias que contiene tu teléfono móvil: así podrás desinfectarlo

Cerradas al baño las playas valencianas de Malvarrosa y de la Devesa por el nivel de bacterias
Investigadores españoles diseñan antibióticos que atacan solo las bacterias 'malas' y evitan resistencias

Las pantallas de los móviles pueden contener hasta seis tipos de bacterias que ponen en riesgo la salud

Las cuatro nuevas enfermedades de transmisión sexual que se están propagando peligrosamente

Un estudio revela que una bacteria se ha hecho inmune a los desinfectantes de manos de los hospitales

Casi 100 personas mueren al día en hospitales españoles por bacterias multirresistentes

Casi 100 personas mueren al día en hospitales españoles por bacterias multirresistentes






